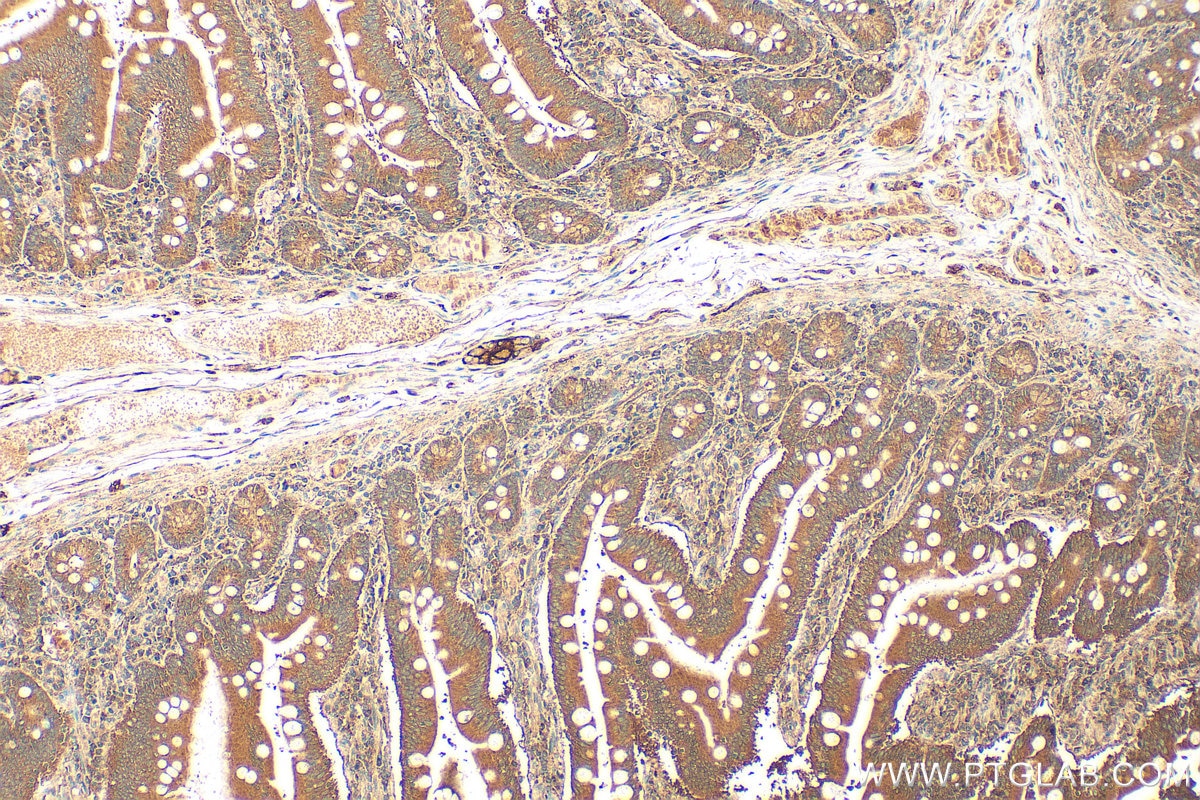
IHC staining of human small intestine using 13656-1-AP Immunohistochemistry (IHC) staining of human small intestine tissue using ENTPD2 Polyclonal antibody (13656-1-AP)
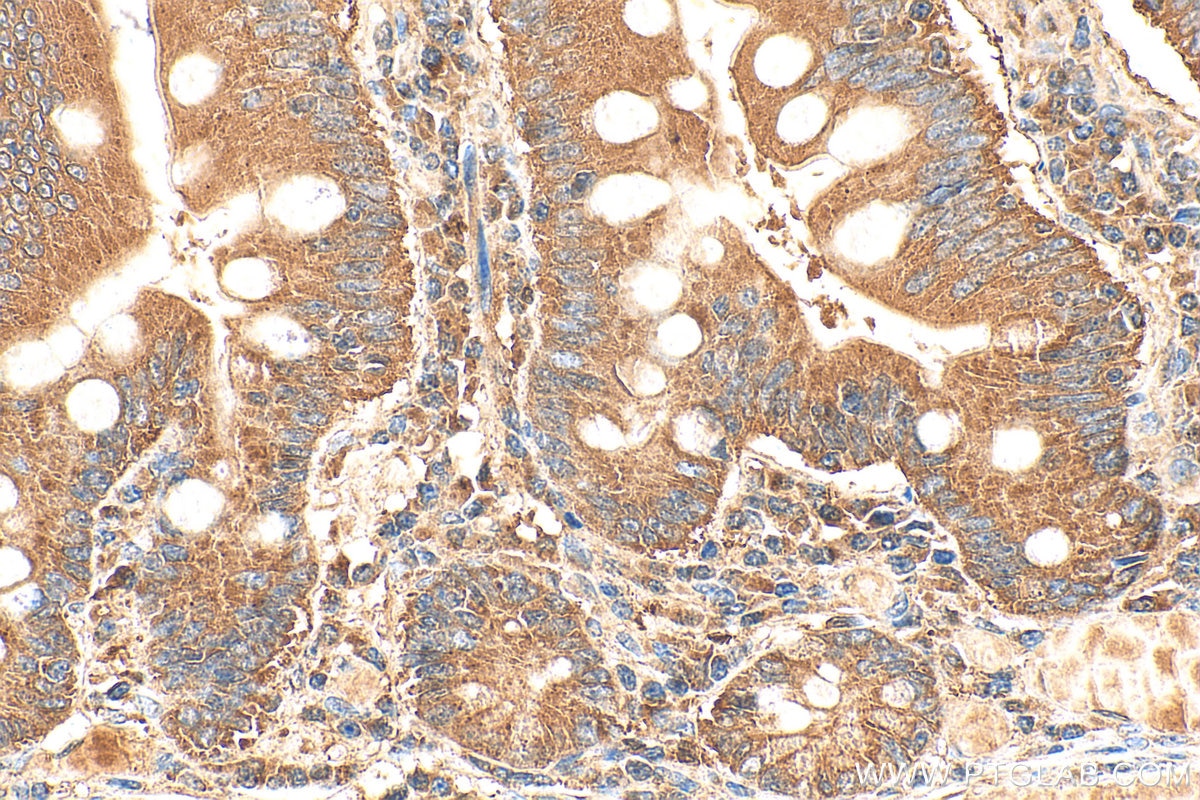
IHC staining of human small intestine using 13656-1-AP Immunohistochemistry (IHC) staining of human small intestine tissue using ENTPD2 Polyclonal antibody (13656-1-AP)

Tested Applications
| Positive WB detected in | human placenta tissue, K-562 cells |
| Positive IP detected in | K-562 cells |
| Positive IHC detected in | human small intestine tissue Note: suggested antigen retrieval with TE buffer pH 9.0; (*) Alternatively, antigen retrieval may be performed with citrate buffer pH 6.0 |
Recommended dilution
| Application | Dilution |
|---|---|
| Western Blot (WB) | WB : 1:1000-1:4000 |
| Immunoprecipitation (IP) | IP : 0.5-4.0 ug for 1.0-3.0 mg of total protein lysate |
| Immunohistochemistry (IHC) | IHC : 1:50-1:500 |
| It is recommended that this reagent should be titrated in each testing system to obtain optimal results. | |
| Sample-dependent, Check data in validation data gallery. | |
Published Applications
| WB | See 1 publications below |
| IHC | See 2 publications below |
Product Information
13656-1-AP targets ENTPD2 in WB, IHC, IP, ELISA applications and shows reactivity with human samples.
| Tested Reactivity | human |
| Cited Reactivity | human, mouse, rat |
| Host / Isotype | Rabbit / IgG |
| Class | Polyclonal |
| Type | Antibody |
| Immunogen |
CatNo: Ag4513 Product name: Recombinant human ENTPD2 protein Source: e coli.-derived, PGEX-4T Tag: GST Domain: 38-323 aa of BC035738 Sequence: LKYGIVLDAGSSHTSMFIYKWPADKENDTGIVGQHSSCDVPGGGISSYADNPSGASQSLVGCLEQALQDVPKERHAGTPLYLGATAGMRLLNLTNPEASTSVLMAVTHTLTQYPFDFRGARILSGQEEGVFGWVTANYLLENFIKYGWVGRWFRPRKGTLGAMDLGGASTQITFETTSPAEDRASEVQLHLYGQHYRVYTHSFLCYGRDQVLQRLLASALQTHGFHPCWPRGFSTQVLLGDVYQSPCTMAQRPQNFNSSARVSLSGSSDPHLCRDLVSGLFSFSSC Predict reactive species |
| Full Name | ectonucleoside triphosphate diphosphohydrolase 2 |
| Calculated Molecular Weight | 495 aa, 54 kDa |
| Observed Molecular Weight | 70 kDa |
| GenBank Accession Number | BC035738 |
| Gene Symbol | ENTPD2 |
| Gene ID (NCBI) | 954 |
| RRID | AB_2877966 |
| Conjugate | Unconjugated |
| Form | Liquid |
| Purification Method | Antigen affinity purification |
| UNIPROT ID | Q9Y5L3 |
| Storage Buffer | PBS with 0.02% sodium azide and 50% glycerol, pH 7.3. |
| Storage Conditions | Store at -20°C. Stable for one year after shipment. Aliquoting is unnecessary for -20oC storage. 20ul sizes contain 0.1% BSA. |
Background Information
ENTPD2(Ectonucleoside triphosphate diphosphohydrolase 2) is also named as CD39L1, Ecto-ATPase 2 and belongs to the GDA1/CD39 NTPase family. In the nervous system, it could hydrolyze ATP and other nucleotides to regulate purinergic neurotransmission. This protein has 3 isoforms produced by alternative splicing.
Protocols
| Product Specific Protocols | |
|---|---|
| IHC protocol for ENTPD2 antibody 13656-1-AP | Download protocol |
| IP protocol for ENTPD2 antibody 13656-1-AP | Download protocol |
| WB protocol for ENTPD2 antibody 13656-1-AP | Download protocol |
| Standard Protocols | |
|---|---|
| Click here to view our Standard Protocols |
Publications
| Species | Application | Title |
|---|---|---|
Am J Physiol Gastrointest Liver Physiol Water intake accelerates ATP release from myofibroblast cells in rats: ATP-mediated podoplanin-dependent control for physiological function and immunity. | ||
Cell Commun Signal Tumor derived exosomal ENTPD2 impair CD8+ T cell function in colon cancer through ATP-adenosine metabolism reprogramming |